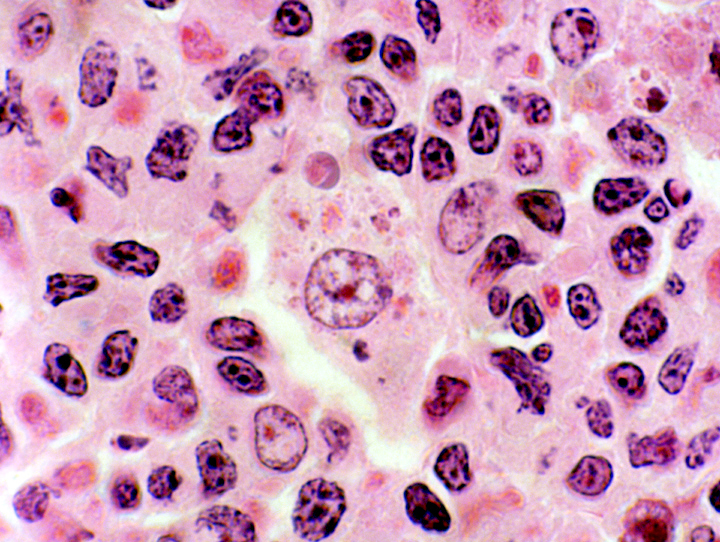
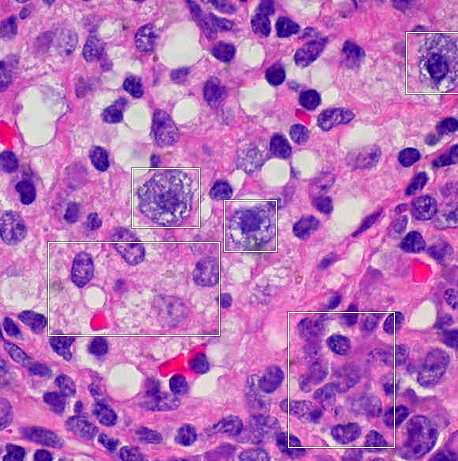

Name 4 important functions of connective tissue
•Connect epithelium to the rest of the body (basal lamina)
•Provide structure (bone)
•Store energy (fat)
•Transport materials (blood)
*Have no contact with environment*
Characteristic components of connective tissue include: (3)
- Specialized cells
- Solid extracellular protein fibers
- Fluid extracellular ground substance
What structure:
– makes up the majority of cell volume
– determines specialized function
the cell matrix
3 classifications of CT are:
(name & function)
•Connective tissue proper:
–connect and protect
•Fluid connective tissues:
–transport
•Supportive connective tissues:
–structural strength
What type of CT is this?
What are its subcategories (2)?

CT Proper
•Loose connective tissue:
–more ground substance, less fibers
–e.g., fat (adipose tissue)
•Dense connective tissue:
–more fibers, less ground substance
–e.g., tendons
8 Cell Types of
Connective Tissue Proper are:
- Fibroblasts
- Macrophages
- Adipocytes
- Mesenchymal cells
- Melanocytes
- Mast cells
- Lymphocytes
- Microphages
Fibroblasts
(most abundant cell type)
- In what type of CT are they found?
- what do they secrete?

–found in all connective tissue proper
–secrete proteins and hyaluronan (cellular cement)
Macrophages
- size/shape?
- involved in what system?
- main function?
- Fixed vs. Free?
- Large, amoeba-like cells
- function in the immune system
- function: eat pathogens and damaged cells
- Fixed macrophages stay in tissue vs. Free macrophages migrate
Adipocytes
- cell type?
- function?

- fat cells
- each cell stores a single, large fat droplet
Mesenchymal Cells
- type of cell?
- responds to?
- differentiates into?
- main functions?

- Stem cells
- respond to injury or infection
- differentiate into: fibroblasts, macrophages, etc.
- repair tissues, regeneration, differentiation

Melanocytes
function?

•Synthesize and store the brown pigment melanin
Mast Cells
- stimulate?
- releases?
- mast cells carried by blood are called?
- Stimulate inflammation after injury or infection
- release histamine and heparin (immunoresponse)
- Basophils
Which of the following is NOT a fiber found in connective tissue?
a. Collagen fiber
b. Elastic fiber
c. Reticular fiber
d. Purkinje fiber
e. All of the above are fibers found in connective tissue
Answer: d
Purkinje fibers are seen in the heart. Purkinje fibers are specialized muscle fibers.
- Which of the following can be classified as “embryonic connective tissue”?
a. Cartilage
b. Mucous connective tissue
d. Adipose tissue
d. Bone
e. Blood
Answer: b
Embryonic connective tissue includes mesenchyme and mucous connective tissue.
- What type of adipose tissue tends to increase as humans age?
a. Brown adipose tissue
b. White adipose tissue
c. Unilocular adipose tissue
d. Multilocular adipose tissue
e. Both b and c
Answer: e
Brown adipose tissue is multilocular adipose tissue. This is present during fetal development and then decreases after birth.
White adipose tissue is unilocular adipose tissue. This type of tissue persists into adulthood.
What color do elastic fibers stain with Verhoeff Elastic stain?
a. Red/Orange
b. Pink/red
c. Purple/Red
d. Blue/black
e. Green/blue
Answer: d
Verhoeff Elastic stain stains elastic fibers blue/black. Collagen stains pink/red.
Which connective tissue cell type produces the ground substance in connective tissue?
a. Fibroblast
b. Myofibroblast
c. Histiocyte
d. Plasma cell
e. Mast cell
Answer: a
Fibroblasts produce collagen. The fibroblast also produces the ground substance in connective tissue.
Which connective tissue cell is derived from B lymphocytes?
a. Fibroblast
b. Myofibroblast
c. Histiocyte
d. Plasma cell
e. Mast cell
Answer: d
Plasma cells are derived from B lymphocytes.
What type of connective tissue is an undifferentiated tissue found in the embryo?
a. Mucous connective tissue
b. Mesenchyme
c. Loose irregular connective tissue
d. Dense irregular connective tissue
e. Dense regular connective tissue
Answer: b
Mesenchyme is embryonic connective tissue. It is an undifferentiated tissue found in the embryo.
Which of the following is not associated with connective tissue?
a. Tightly packed cells
b. Extracellular fibers
c. Tissue fluid
d. Ground substance
e. None of the above; all of the above are seen with connective tissue
Answer: a
Connective tissue consists of cells and extracellular fibers in a ground substance and tissue fluid. There is generally abundant extracellular space in connective tissue; the cells are not tightly packed.
Which of the following would be best suited to visualize lipid?
a. Wright’s stain
b. Hematoxylin and eosin stain
c. Sudan stain
d. Silver impregnation
e. Masson’s trichrome stain
Answer: c
A peripheral blood smear would be best visualized with Wright’s stain. Hematoxylin and eosin stain is the most commonly used tissue stain for routine histological examination. Lipids are best displayed with a sudan stain. Silver impregnation, such as with a reticular stain, can be used to visualize reticular fibers. Collagen fibers can be differentiated from other fibers by staining with Masson’s trichrome stain.
Which of the following can be classified as “specialized connective tissue”?
a. Loose connective tissue
b. Mesenchyme
c. Adipose tissue
d. Mucous connective tissue
e. Dense connective tissue
Answer: c
Specialized connective tissue includes cartilage, bone, adipose tissue, blood and hemopoietic tissue, and lymphatic tissue.
What type of adipose tissue tends to decrease as humans age?
a. Brown adipose tissue
b. White adipose tissue
c. Unilocular adipose tissue
d. Multilocular adipose tissue
e. Both a and d
Answer: e
Brown adipose tissue is multilocular adipose tissue. This is present during fetal development and then decreases after birth.
Which of the following would be best suited to visualize reticular fibers?
a. Wright’s stain
b. Hematoxylin and eosin stain
c. Sudan stain
d. Silver impregnation
e. Masson’s trichrome stain
Answer: d
A peripheral blood smear would be best visualized with Wright’s stain. Hematoxylin and eosin stain is the most commonly used tissue stain for routine histological examination. Lipids are best displayed with a sudan stain. Silver impregnation, such as with a reticular stain, can be used to visualize reticular fibers. Collagen fibers can be differentiated from other fibers by staining with Masson’s trichrome stain.


